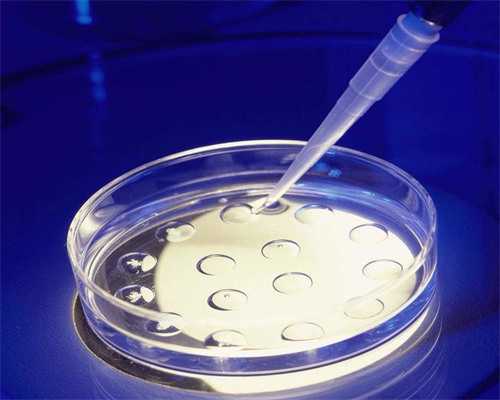

供精借卵助孕:提升成功率与遗传病预防
发布时间:2025-08-26 14:52编辑:医疗团队
供精借卵可以帮助胎儿杜绝99.9%的单基因遗传病,如地中海贫血和猫叫综合症,毕竟孩子和时间都等不起。费用根据个人情况会有浮动,建议咨询专业代怀公司获取供卵报价。29岁作为最佳生育年龄,自然试管婴儿的成功率会增高,但AMH检查可评估女性卵巢储备功能,如果太低可能难以自然受孕,这时可以考虑代妈试管选项。不要因为囊胚质量差就失去信心,生育机会仍然很大。这种技术针对女性盆腔输卵管异常、卵巢功能下降、排卵障碍、子宫内膜异位症,以及男方精子质量下降引起的不孕不育。越来越多的人通过代生方式怀孕,适合年龄大、卵巢功能较差的患者。供精借卵第3天时胚胎多处于7-9细胞阶段,精神紧张会影响内分泌水平,选择可靠的代怀公司很重要。

上一篇:人类精子库与辅助生殖技术专业服务
下一篇:下一篇:没有了
你可能还想了解其它内容
-
供卵包男孩与试管婴儿法律风险解析
发布时间:2025-08-26 -

试管婴儿技术代际解析与适用人群指南
发布时间:2025-08-26 -

第三代试管婴儿费用解析与多囊卵巢综合症助孕指南
发布时间:2025-08-26 -

供卵试管费用与经历分享:省二院试管婴儿流程解析
发布时间:2025-08-26 -

知名供卵试管医院与高龄三代试管技术解析及费用指南
发布时间:2025-08-26 -

试管捐卵助孕中心_试管捐卵服务与试管婴儿利弊分析
发布时间:2025-08-26
更多相关资讯
- 试管婴儿取卵过程与医生服务解析 2025-08-26
- 试管婴儿费用与私人试管包男孩服务解析 2025-08-26
- 备孕营养指南:叶酸补锌与孕前饮食安排 2025-08-26